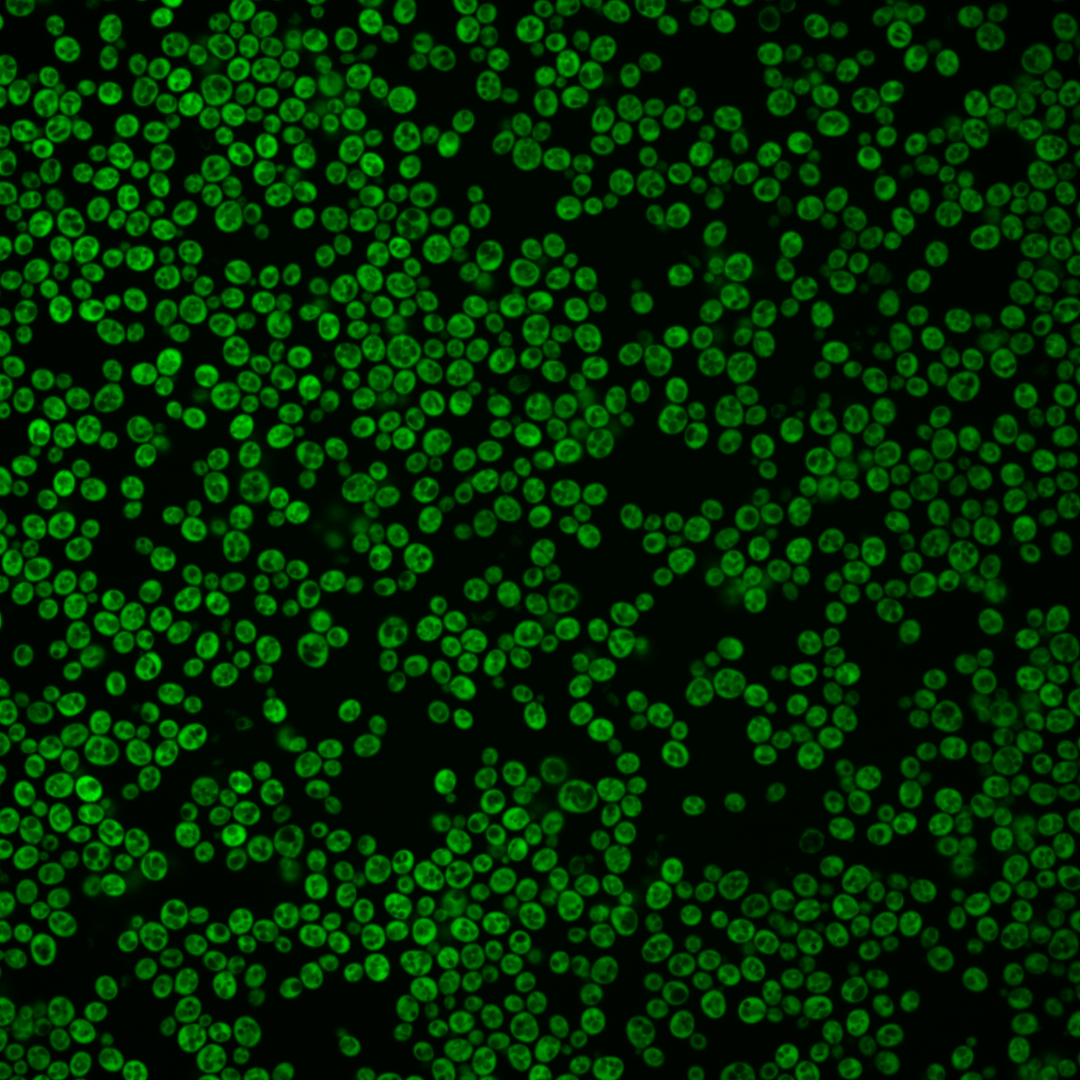
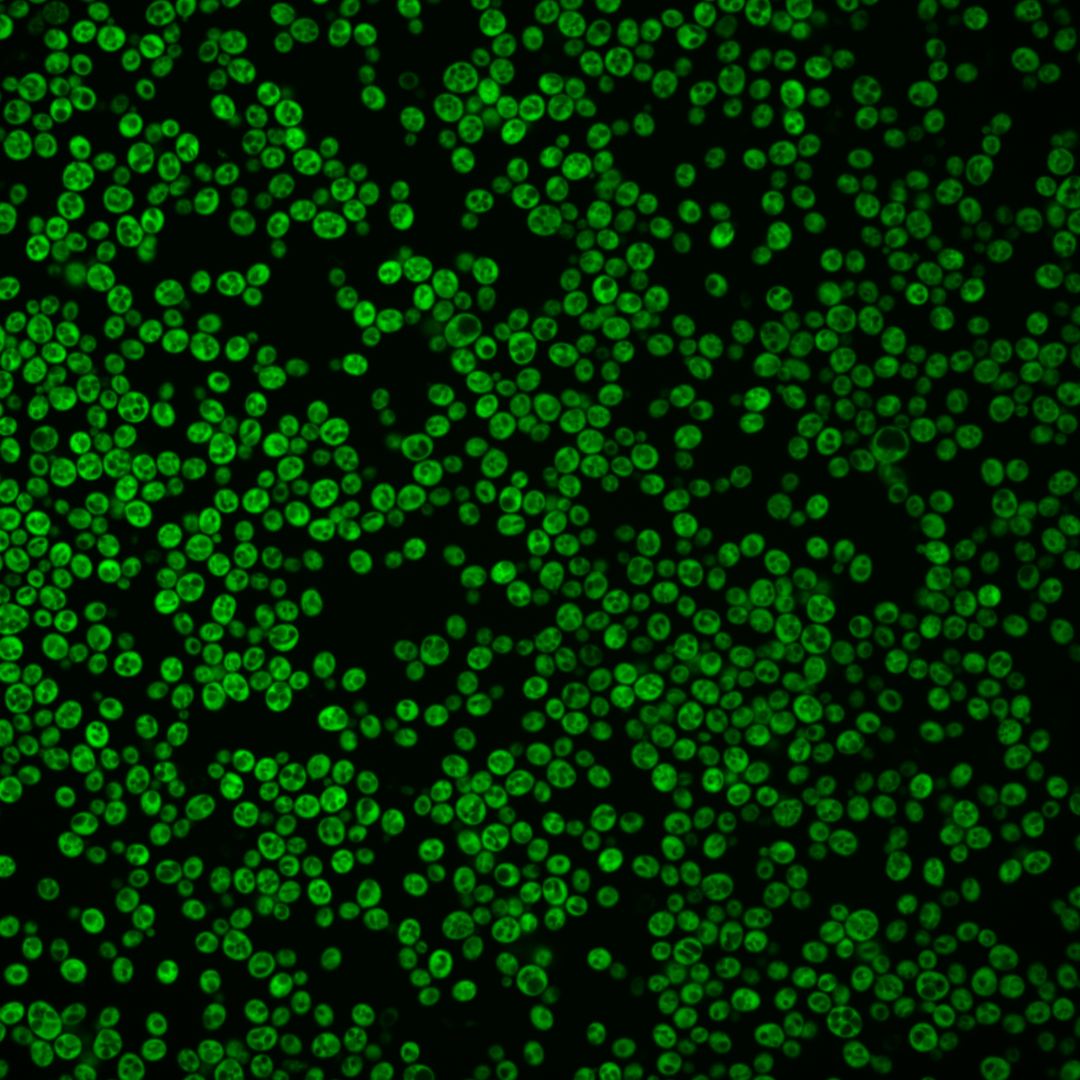
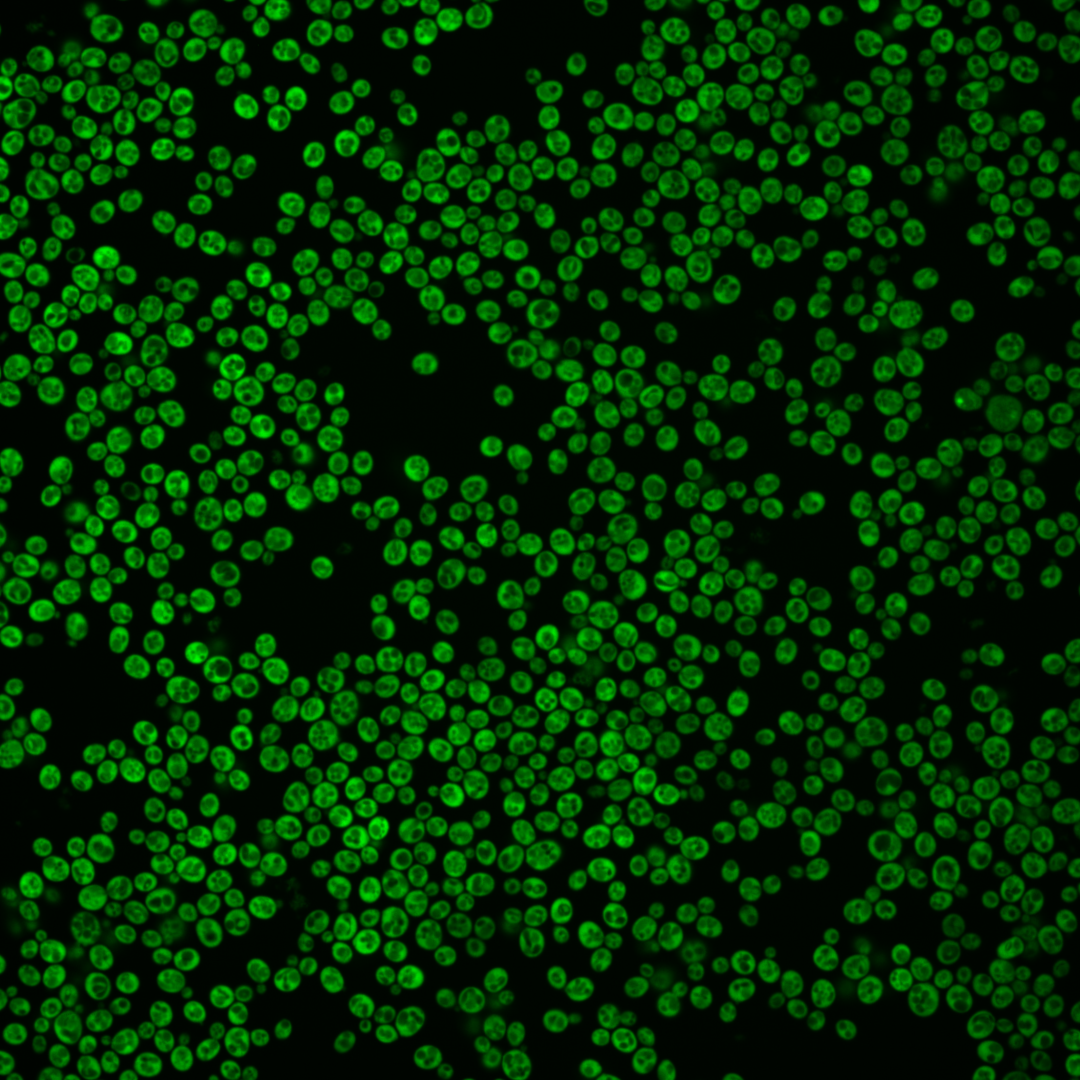
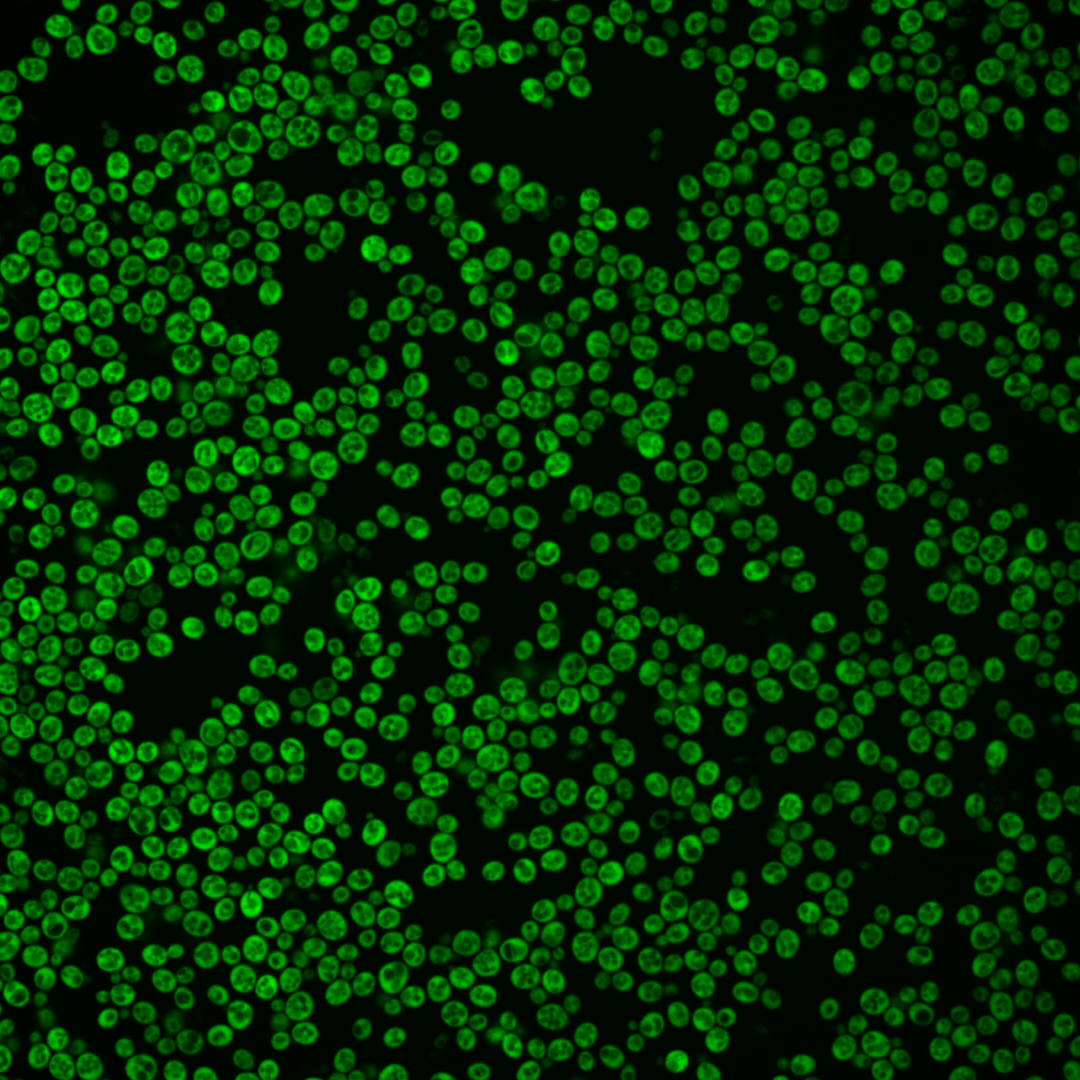
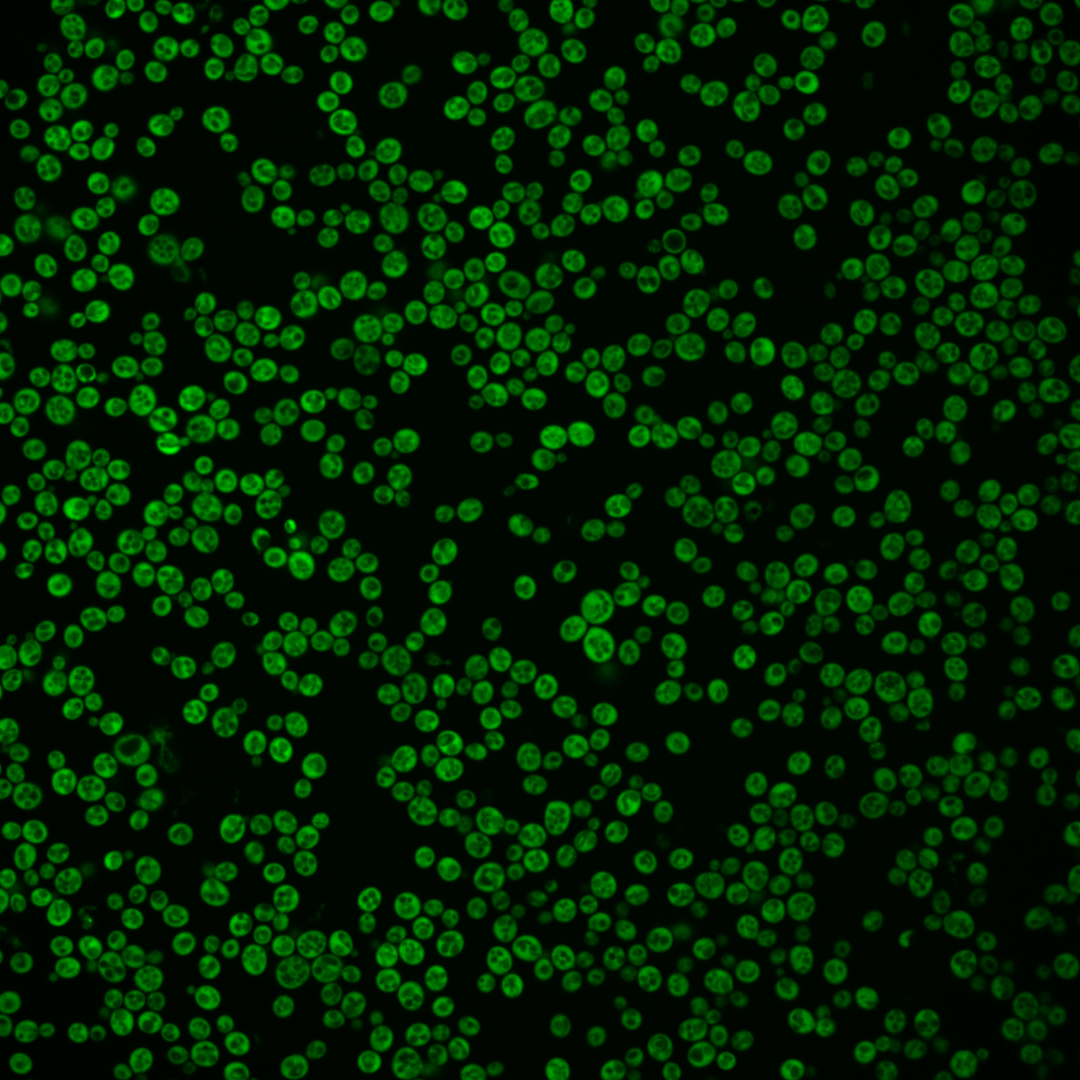
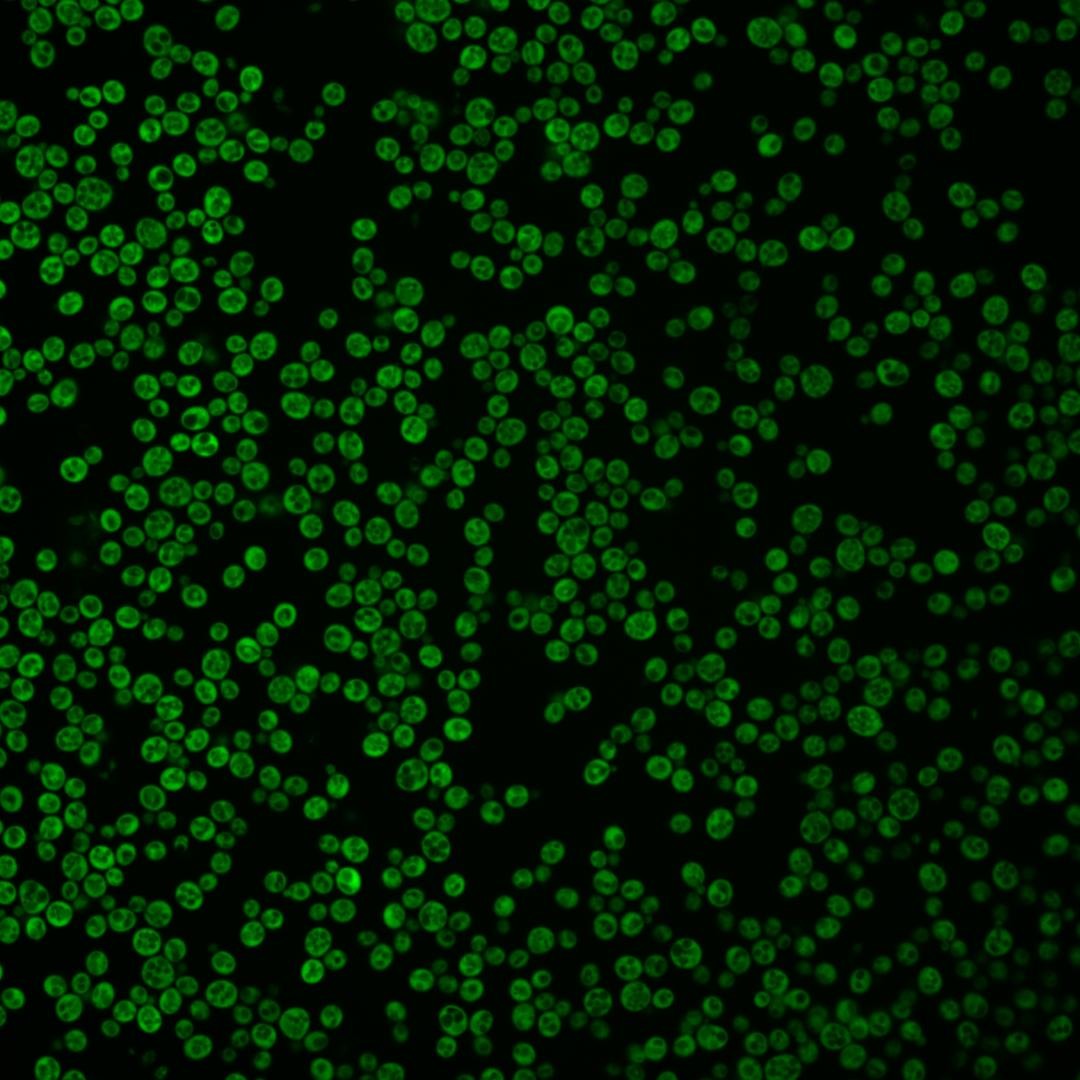
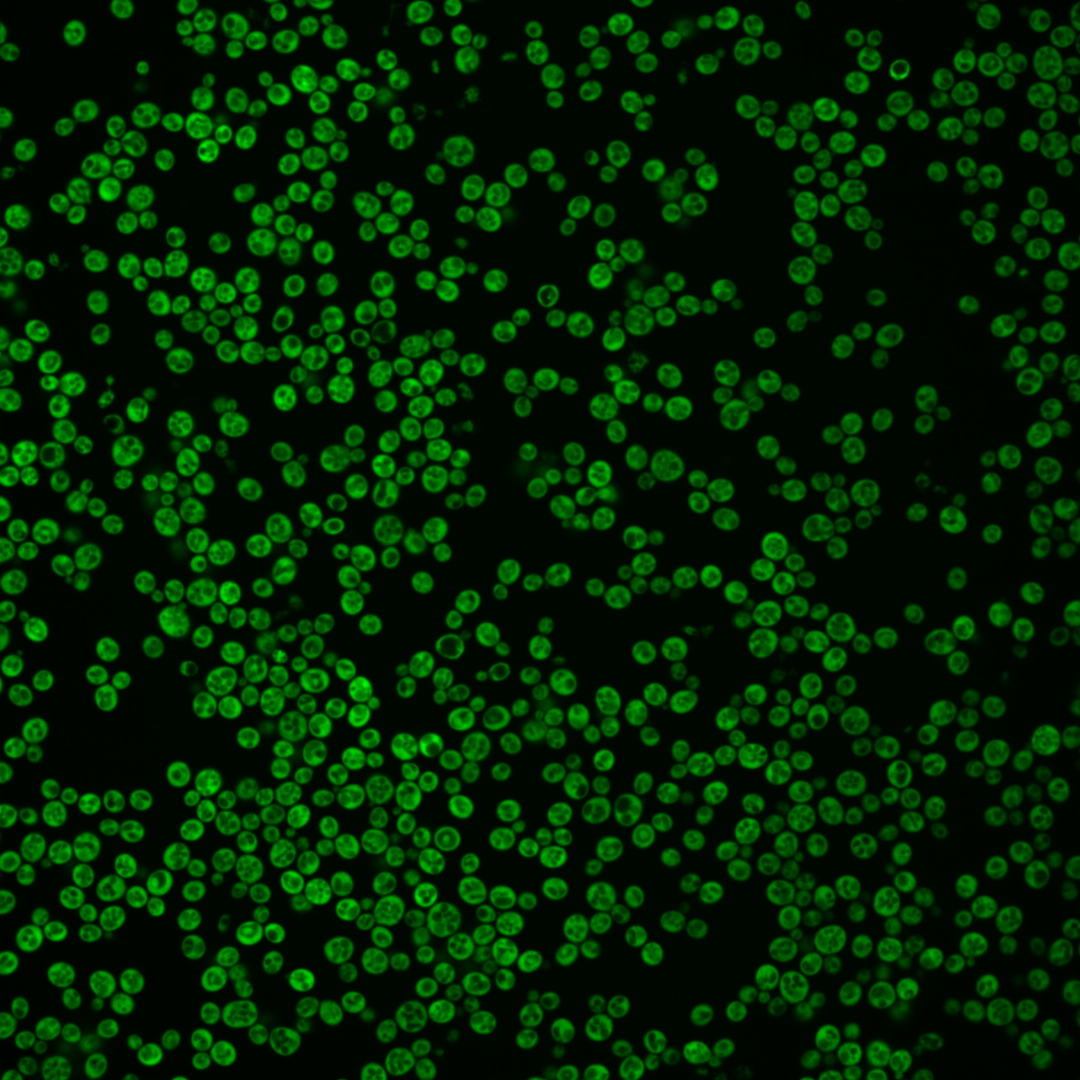

| Standard name | |
|---|---|
| Human Ortholog | |
| Description | Ribosomal 60S subunit protein L18B; homologous to mammalian ribosomal protein L18, no bacterial homolog; RPL18B has a paralog, RPL18A, that arose from the whole genome duplication |
Micrographs




















































































Sub-cellular Localization
Yeast GFP Assignment
Protein Abundance
Localization Change
External localization resources
| ensLOC | DeepLoc | |||||||||||||||||||||||
|---|---|---|---|---|---|---|---|---|---|---|---|---|---|---|---|---|---|---|---|---|---|---|---|---|
| Localization | WT1 | WT2 | WT3 | RAP60 | RAP140 | RAP220 | RAP300 | RAP380 | RAP460 | RAP540 | RAP620 | RAP700 | HU80 | HU120 | HU160 | rpd3Δ_1 | rpd3Δ_2 | rpd3Δ_3 | WT1 | WT2 | WT3 | AF100 | AF140 | AF180 |
| Cortical Patches | 0 | 0 | 0 | 0 | 0 | 5 | 13 | 11 | 21 | 23 | 18 | 25 | 0 | 0 | 0 | 0 | 0 | 0 | 0 | 0 | 0 | 0 | 0 | 0 |
| Bud | 1 | 2 | 1 | 0 | 0 | 1 | 2 | 1 | 0 | 3 | 4 | 1 | 0 | 0 | 1 | 0 | 0 | 0 | 1 | 0 | 2 | 0 | 2 | 2 |
| Bud Neck | 0 | 0 | 0 | 0 | 0 | 0 | 0 | 0 | 0 | 0 | 0 | 0 | 0 | 0 | 0 | 0 | 0 | 0 | 0 | 0 | 0 | 0 | 0 | 0 |
| Bud Site | 0 | 0 | 0 | 0 | 0 | 0 | 0 | 0 | 0 | 0 | 0 | 0 | 0 | 0 | 0 | 0 | 0 | 0 | – | – | – | – | – | – |
| Cell Periphery | 1 | 0 | 3 | 6 | 11 | 9 | 25 | 26 | 32 | 27 | 24 | 34 | 2 | 1 | 4 | 8 | 8 | 12 | 0 | 0 | 0 | 0 | 0 | 0 |
| Cytoplasm | 339 | 99 | 150 | 277 | 376 | 288 | 387 | 359 | 271 | 312 | 249 | 265 | 164 | 346 | 377 | 267 | 211 | 184 | 326 | 93 | 140 | 143 | 305 | 306 |
| Endoplasmic Reticulum | 2 | 1 | 1 | 4 | 17 | 35 | 71 | 114 | 95 | 93 | 63 | 118 | 1 | 10 | 7 | 12 | 10 | 6 | 4 | 0 | 2 | 2 | 7 | 13 |
| Endosome | 0 | 0 | 0 | 0 | 0 | 0 | 0 | 0 | 0 | 0 | 0 | 0 | 0 | 0 | 0 | 0 | 0 | 0 | 0 | 0 | 0 | 0 | 0 | 0 |
| Golgi | 0 | 0 | 1 | 0 | 5 | 5 | 5 | 5 | 7 | 14 | 11 | 12 | 0 | 0 | 1 | 1 | 1 | 0 | 0 | 0 | 0 | 0 | 0 | 0 |
| Mitochondria | 0 | 0 | 0 | 0 | 0 | 0 | 3 | 2 | 14 | 12 | 17 | 15 | 0 | 0 | 0 | 0 | 0 | 0 | 0 | 0 | 0 | 0 | 1 | 0 |
| Nucleus | 0 | 0 | 0 | 1 | 0 | 1 | 1 | 1 | 1 | 1 | 0 | 1 | 0 | 0 | 0 | 0 | 0 | 0 | 0 | 0 | 0 | 1 | 0 | 0 |
| Nuclear Periphery | 0 | 0 | 0 | 0 | 0 | 0 | 0 | 0 | 1 | 0 | 0 | 1 | 0 | 0 | 0 | 0 | 0 | 0 | 0 | 0 | 0 | 0 | 0 | 0 |
| Nucleolus | 0 | 0 | 0 | 0 | 0 | 0 | 0 | 0 | 2 | 0 | 1 | 1 | 0 | 0 | 0 | 0 | 0 | 0 | 0 | 0 | 0 | 0 | 0 | 0 |
| Peroxisomes | 0 | 0 | 0 | 0 | 0 | 0 | 0 | 0 | 0 | 0 | 0 | 0 | 0 | 0 | 0 | 0 | 0 | 0 | 0 | 0 | 0 | 0 | 0 | 0 |
| SpindlePole | 0 | 0 | 0 | 0 | 0 | 0 | 0 | 0 | 0 | 0 | 0 | 0 | 0 | 0 | 0 | 0 | 0 | 0 | 0 | 0 | 0 | 0 | 0 | 0 |
| Vac/Vac Membrane | 0 | 0 | 1 | 2 | 1 | 2 | 4 | 3 | 2 | 19 | 6 | 21 | 0 | 0 | 3 | 2 | 1 | 1 | 0 | 0 | 0 | 1 | 1 | 2 |
| Unique Cell Count | 341 | 101 | 154 | 283 | 396 | 332 | 481 | 495 | 400 | 457 | 360 | 440 | 165 | 352 | 384 | 272 | 215 | 188 | 335 | 99 | 147 | 153 | 323 | 332 |
| Labelled Cell Count | 343 | 102 | 157 | 290 | 410 | 346 | 511 | 522 | 446 | 504 | 393 | 494 | 167 | 357 | 393 | 290 | 231 | 203 | 335 | 99 | 147 | 153 | 323 | 332 |
Yeast GFP Assignment
Protein Abundance
| Screen | WT1 | WT2 | WT3 | RAP60 | RAP140 | RAP220 | RAP300 | RAP380 | RAP460 | RAP540 | RAP620 | RAP700 | HU80 | HU120 | HU160 | rpd3Δ_1 | rpd3Δ_2 | rpd3Δ_3 | AF100 | AF140 | AF180 |
|---|---|---|---|---|---|---|---|---|---|---|---|---|---|---|---|---|---|---|---|---|---|
| Mean Cell GFP Intensity (1e-4) | 70.5 | 91.1 | 68.1 | 67.5 | 53.3 | 39.7 | 34.5 | 34.0 | 28.8 | 27.7 | 25.1 | 24.6 | 82.5 | 79.0 | 76.3 | 109.4 | 130.7 | 132.7 | 76.2 | 81.2 | 86.9 |
| Std Deviation (1e-4) | 13.8 | 22.2 | 15.5 | 15.0 | 9.9 | 8.8 | 8.0 | 7.0 | 6.4 | 6.2 | 6.1 | 5.2 | 19.4 | 18.5 | 18.3 | 27.9 | 31.8 | 30.6 | 21.6 | 22.7 | 24.5 |
| Intensity Change (Log2) | – | – | – | -0.01 | -0.36 | -0.78 | -0.98 | -1.0 | -1.24 | -1.3 | -1.44 | -1.47 | 0.28 | 0.21 | 0.16 | 0.68 | 0.94 | 0.96 | 0.16 | 0.25 | 0.35 |
Localization Change
| Localization | RAP60 | RAP140 | RAP220 | RAP300 | RAP380 | RAP460 | RAP540 | RAP620 | RAP700 | HU80 | HU120 | HU160 | rpd3Δ_1 | rpd3Δ_2 | rpd3Δ_3 |
|---|---|---|---|---|---|---|---|---|---|---|---|---|---|---|---|
| Cortical Patches | 0 | 0 | 0 | 0 | 0 | 2.9 | 2.8 | 2.8 | 3.0 | 0 | 0 | 0 | 0 | 0 | 0 |
| Bud | 0 | 0 | 0 | 0 | 0 | 0 | 0 | 0 | 0 | 0 | 0 | 0 | 0 | 0 | 0 |
| Bud Neck | 0 | 0 | 0 | 0 | 0 | 0 | 0 | 0 | 0 | 0 | 0 | 0 | 0 | 0 | 0 |
| Bud Site | 0 | 0 | 0 | 0 | 0 | 0 | 0 | 0 | 0 | 0 | 0 | 0 | 0 | 0 | 0 |
| Cell Periphery | 0 | 0 | 0 | 1.7 | 1.7 | 2.6 | 2.0 | 2.2 | 2.6 | 0 | 0 | 0 | 0 | 0 | 2.0 |
| Cytoplasm | 0.3 | -1.3 | -3.7 | -5.1 | -6.6 | -7.3 | -7.3 | -7.0 | -8.7 | 1.4 | 0.7 | 0.6 | 0.5 | 0.5 | 0.3 |
| Endoplasmic Reticulum | 0 | 2.2 | 3.9 | 4.8 | 6.4 | 6.4 | 5.9 | 5.3 | 7.0 | 0 | 0 | 0 | 0 | 0 | 0 |
| Endosome | 0 | 0 | 0 | 0 | 0 | 0 | 0 | 0 | 0 | 0 | 0 | 0 | 0 | 0 | 0 |
| Golgi | 0 | 0 | 0 | 0 | 0 | 0 | 0 | 0 | 0 | 0 | 0 | 0 | 0 | 0 | 0 |
| Mitochondria | 0 | 0 | 0 | 0 | 0 | 0 | 0 | 2.7 | 0 | 0 | 0 | 0 | 0 | 0 | 0 |
| Nucleus | 0 | 0 | 0 | 0 | 0 | 0 | 0 | 0 | 0 | 0 | 0 | 0 | 0 | 0 | 0 |
| Nuclear Periphery | 0 | 0 | 0 | 0 | 0 | 0 | 0 | 0 | 0 | 0 | 0 | 0 | 0 | 0 | 0 |
| Nucleolus | 0 | 0 | 0 | 0 | 0 | 0 | 0 | 0 | 0 | 0 | 0 | 0 | 0 | 0 | 0 |
| Peroxisomes | 0 | 0 | 0 | 0 | 0 | 0 | 0 | 0 | 0 | 0 | 0 | 0 | 0 | 0 | 0 |
| SpindlePole | 0 | 0 | 0 | 0 | 0 | 0 | 0 | 0 | 0 | 0 | 0 | 0 | 0 | 0 | 0 |
| Vacuole | 0 | 0 | 0 | 0 | 0 | 0 | 2.1 | 0 | 2.3 | 0 | 0 | 0 | 0 | 0 | 0 |
External localization resources
Images






























Protein Concentration and Protein Localization Data
| R1 | R2 | R3 | ||||||||||||||||
|---|---|---|---|---|---|---|---|---|---|---|---|---|---|---|---|---|---|---|
| G1 Pre-START | G1 Post-START | S/G2 | Metaphase | Anaphase | Telophase | G1 Pre-START | G1 Post-START | S/G2 | Metaphase | Anaphase | Telophase | G1 Pre-START | G1 Post-START | S/G2 | Metaphase | Anaphase | Telophase | |
| Concentration | 57.7442 | 75.8009 | 69.3443 | 58.8915 | 63.5618 | 66.8167 | 55.5187 | 84.0174 | 72.3325 | 65.1116 | 60.4982 | 64.0273 | 62.1331 | 79.0967 | 75.8978 | 69.1106 | 63.252 | 66.8636 |
| Actin | 0.0007 | 0.0001 | 0.0001 | 0.0136 | 0.0001 | 0.0002 | 0.0118 | 0.0001 | 0.01 | 0.0111 | 0.0436 | 0.0164 | 0.0013 | 0.0011 | 0.0049 | 0.0003 | 0.0044 | 0.0305 |
| Bud | 0.0004 | 0.0001 | 0.0001 | 0.0008 | 0.0002 | 0.0001 | 0.0004 | 0.0001 | 0.0005 | 0.0013 | 0.0005 | 0.0004 | 0.0005 | 0.0001 | 0.0002 | 0.0006 | 0.0002 | 0.0003 |
| Bud Neck | 0.0004 | 0.0002 | 0.0003 | 0.0006 | 0.0009 | 0.0007 | 0.0011 | 0.0001 | 0.001 | 0.0013 | 0.0014 | 0.001 | 0.0002 | 0.0002 | 0.0002 | 0.0003 | 0.0009 | 0.0004 |
| Bud Periphery | 0.0006 | 0.0001 | 0.0001 | 0.001 | 0.0002 | 0.0002 | 0.0005 | 0 | 0.0003 | 0.0016 | 0.0007 | 0.0002 | 0.0006 | 0 | 0.0002 | 0.0005 | 0.0003 | 0.0002 |
| Bud Site | 0.0002 | 0.0001 | 0 | 0.0007 | 0.0001 | 0 | 0.0024 | 0.0001 | 0.0006 | 0.006 | 0.0012 | 0.0004 | 0.0002 | 0.0001 | 0.0003 | 0.0009 | 0.0021 | 0.0003 |
| Cell Periphery | 0.0042 | 0.0031 | 0.0014 | 0.0027 | 0.0034 | 0.002 | 0.0013 | 0.0002 | 0.0003 | 0.0002 | 0.0001 | 0.0001 | 0.0013 | 0.0013 | 0.0015 | 0.003 | 0.0002 | 0 |
| Cytoplasm | 0.8802 | 0.9632 | 0.9388 | 0.8915 | 0.9311 | 0.9248 | 0.8257 | 0.9902 | 0.8893 | 0.9022 | 0.7253 | 0.9233 | 0.8862 | 0.9732 | 0.9482 | 0.893 | 0.8589 | 0.9283 |
| Cytoplasmic Foci | 0.005 | 0.0006 | 0.0011 | 0.0016 | 0.0011 | 0.0042 | 0.0152 | 0.0006 | 0.0123 | 0.0076 | 0.0085 | 0.0067 | 0.0027 | 0.0006 | 0.0054 | 0.0033 | 0.016 | 0.0027 |
| Eisosomes | 0.0001 | 0 | 0 | 0.0003 | 0 | 0 | 0.0001 | 0 | 0.0002 | 0.0001 | 0.0004 | 0.0001 | 0 | 0 | 0.0001 | 0.0001 | 0.0002 | 0.0002 |
| Endoplasmic Reticulum | 0.0456 | 0.0185 | 0.0246 | 0.012 | 0.0069 | 0.0381 | 0.0195 | 0.0036 | 0.014 | 0.0094 | 0.0327 | 0.0083 | 0.0303 | 0.0151 | 0.0067 | 0.017 | 0.0066 | 0.0086 |
| Endosome | 0.0047 | 0.0009 | 0.0021 | 0.0066 | 0.0055 | 0.0033 | 0.0172 | 0.0008 | 0.005 | 0.0079 | 0.0115 | 0.0068 | 0.0058 | 0.0006 | 0.0037 | 0.0055 | 0.0176 | 0.0066 |
| Golgi | 0.0006 | 0.0001 | 0.0001 | 0.0014 | 0.0001 | 0.0006 | 0.0043 | 0.0001 | 0.0024 | 0.0036 | 0.0085 | 0.0019 | 0.0005 | 0.0002 | 0.003 | 0.0003 | 0.005 | 0.0017 |
| Lipid Particles | 0.0015 | 0.0013 | 0.0008 | 0.0008 | 0.0008 | 0.0003 | 0.0142 | 0.0001 | 0.005 | 0.0037 | 0.014 | 0.003 | 0.0009 | 0.0005 | 0.0021 | 0.0024 | 0.0249 | 0.0018 |
| Mitochondria | 0.0028 | 0.0004 | 0.0002 | 0.0046 | 0.0004 | 0.0018 | 0.0036 | 0 | 0.0079 | 0.0039 | 0.0674 | 0.0007 | 0.0024 | 0.0001 | 0.0024 | 0.0049 | 0.0057 | 0.0016 |
| None | 0.003 | 0.0001 | 0.0003 | 0.0015 | 0.0003 | 0.0012 | 0.0044 | 0.0001 | 0.0019 | 0.0011 | 0.0032 | 0.0015 | 0.0019 | 0.0001 | 0.0013 | 0.0016 | 0.0029 | 0.0003 |
| Nuclear Periphery | 0.0078 | 0.0016 | 0.004 | 0.0077 | 0.0058 | 0.0054 | 0.0187 | 0.001 | 0.0074 | 0.0033 | 0.0492 | 0.0075 | 0.0204 | 0.0021 | 0.0039 | 0.0065 | 0.0221 | 0.0065 |
| Nucleolus | 0.0019 | 0 | 0.0027 | 0.0013 | 0.0002 | 0.0021 | 0.0041 | 0 | 0.0012 | 0.0004 | 0.0005 | 0.0003 | 0.0008 | 0.0001 | 0.0031 | 0.0015 | 0.0014 | 0 |
| Nucleus | 0.005 | 0.001 | 0.0032 | 0.0062 | 0.0062 | 0.0021 | 0.0091 | 0.0007 | 0.0032 | 0.0021 | 0.0015 | 0.0029 | 0.0057 | 0.0007 | 0.0023 | 0.0033 | 0.0023 | 0.0021 |
| Peroxisomes | 0.0005 | 0 | 0 | 0.0002 | 0 | 0.0001 | 0.007 | 0 | 0.0131 | 0.0166 | 0.0131 | 0.0016 | 0.0004 | 0 | 0.0008 | 0.0002 | 0.009 | 0.0023 |
| Punctate Nuclear | 0.0033 | 0 | 0.0001 | 0.0004 | 0 | 0.0002 | 0.0155 | 0 | 0.0014 | 0.0022 | 0.0061 | 0.0118 | 0.0007 | 0 | 0.0003 | 0.0001 | 0.0051 | 0.0001 |
| Vacuole | 0.0267 | 0.008 | 0.0175 | 0.0396 | 0.0294 | 0.0113 | 0.0191 | 0.002 | 0.016 | 0.012 | 0.0074 | 0.0042 | 0.0274 | 0.0037 | 0.0075 | 0.043 | 0.01 | 0.0035 |
| Vacuole Periphery | 0.0048 | 0.0004 | 0.0025 | 0.0051 | 0.0072 | 0.0013 | 0.0047 | 0.0002 | 0.0069 | 0.0026 | 0.0034 | 0.0011 | 0.0096 | 0.0003 | 0.0015 | 0.0116 | 0.0041 | 0.0018 |
Sequencing Data
| R1 | R2 | |||||||||
|---|---|---|---|---|---|---|---|---|---|---|
| G1 Post-START | S/G2 | Metaphase | Anaphase | Telophase | G1 Post-START | S/G2 | Metaphase | Anaphase | Telophase | |
| Gene Expression | 941.1391 | 1114.7282 | 1458.6486 | 1000.9419 | 1290.356 | 973.0532 | 944.88 | 866.9053 | 1108.5895 | 813.2231 |
| Translational Efficiency | 1.0269 | 1.0542 | 0.8869 | 1.3469 | 0.9628 | 0.9178 | 1.1151 | 1.2188 | 0.9852 | 1.2643 |
Hit Data
| Dataset | Hit |
|---|---|
| Protein Concentration | ✔ |
| Protein Localization | ✘ |
| Gene Expression | ✘ |
| Translational Efficiency | ✘ |
Endocytosis
| Temp | Actin Patch (Sac6-tdTomato) | Cortical Patch (Sla1-GFP) | Late Endosome (Snf7-GFP) | Vacuole (Vph1-GFP) |
|---|---|---|---|---|
| 37℃ | ||||
| RT |
Cell Cycle Omics
CYCLoPs (Rpl18b-GFP)
| Gene / Allele | Actin Patch (Sac6-tdTomato) | Cortical Patch (Sla1-GFP) | Late Endosome (Snf7-GFP) | Vacuole (Sac6-tdTomato) |
|---|
| Gene | Images |
|---|
| Gene | Images |
|---|
Images are not yet available
Images are not yet available